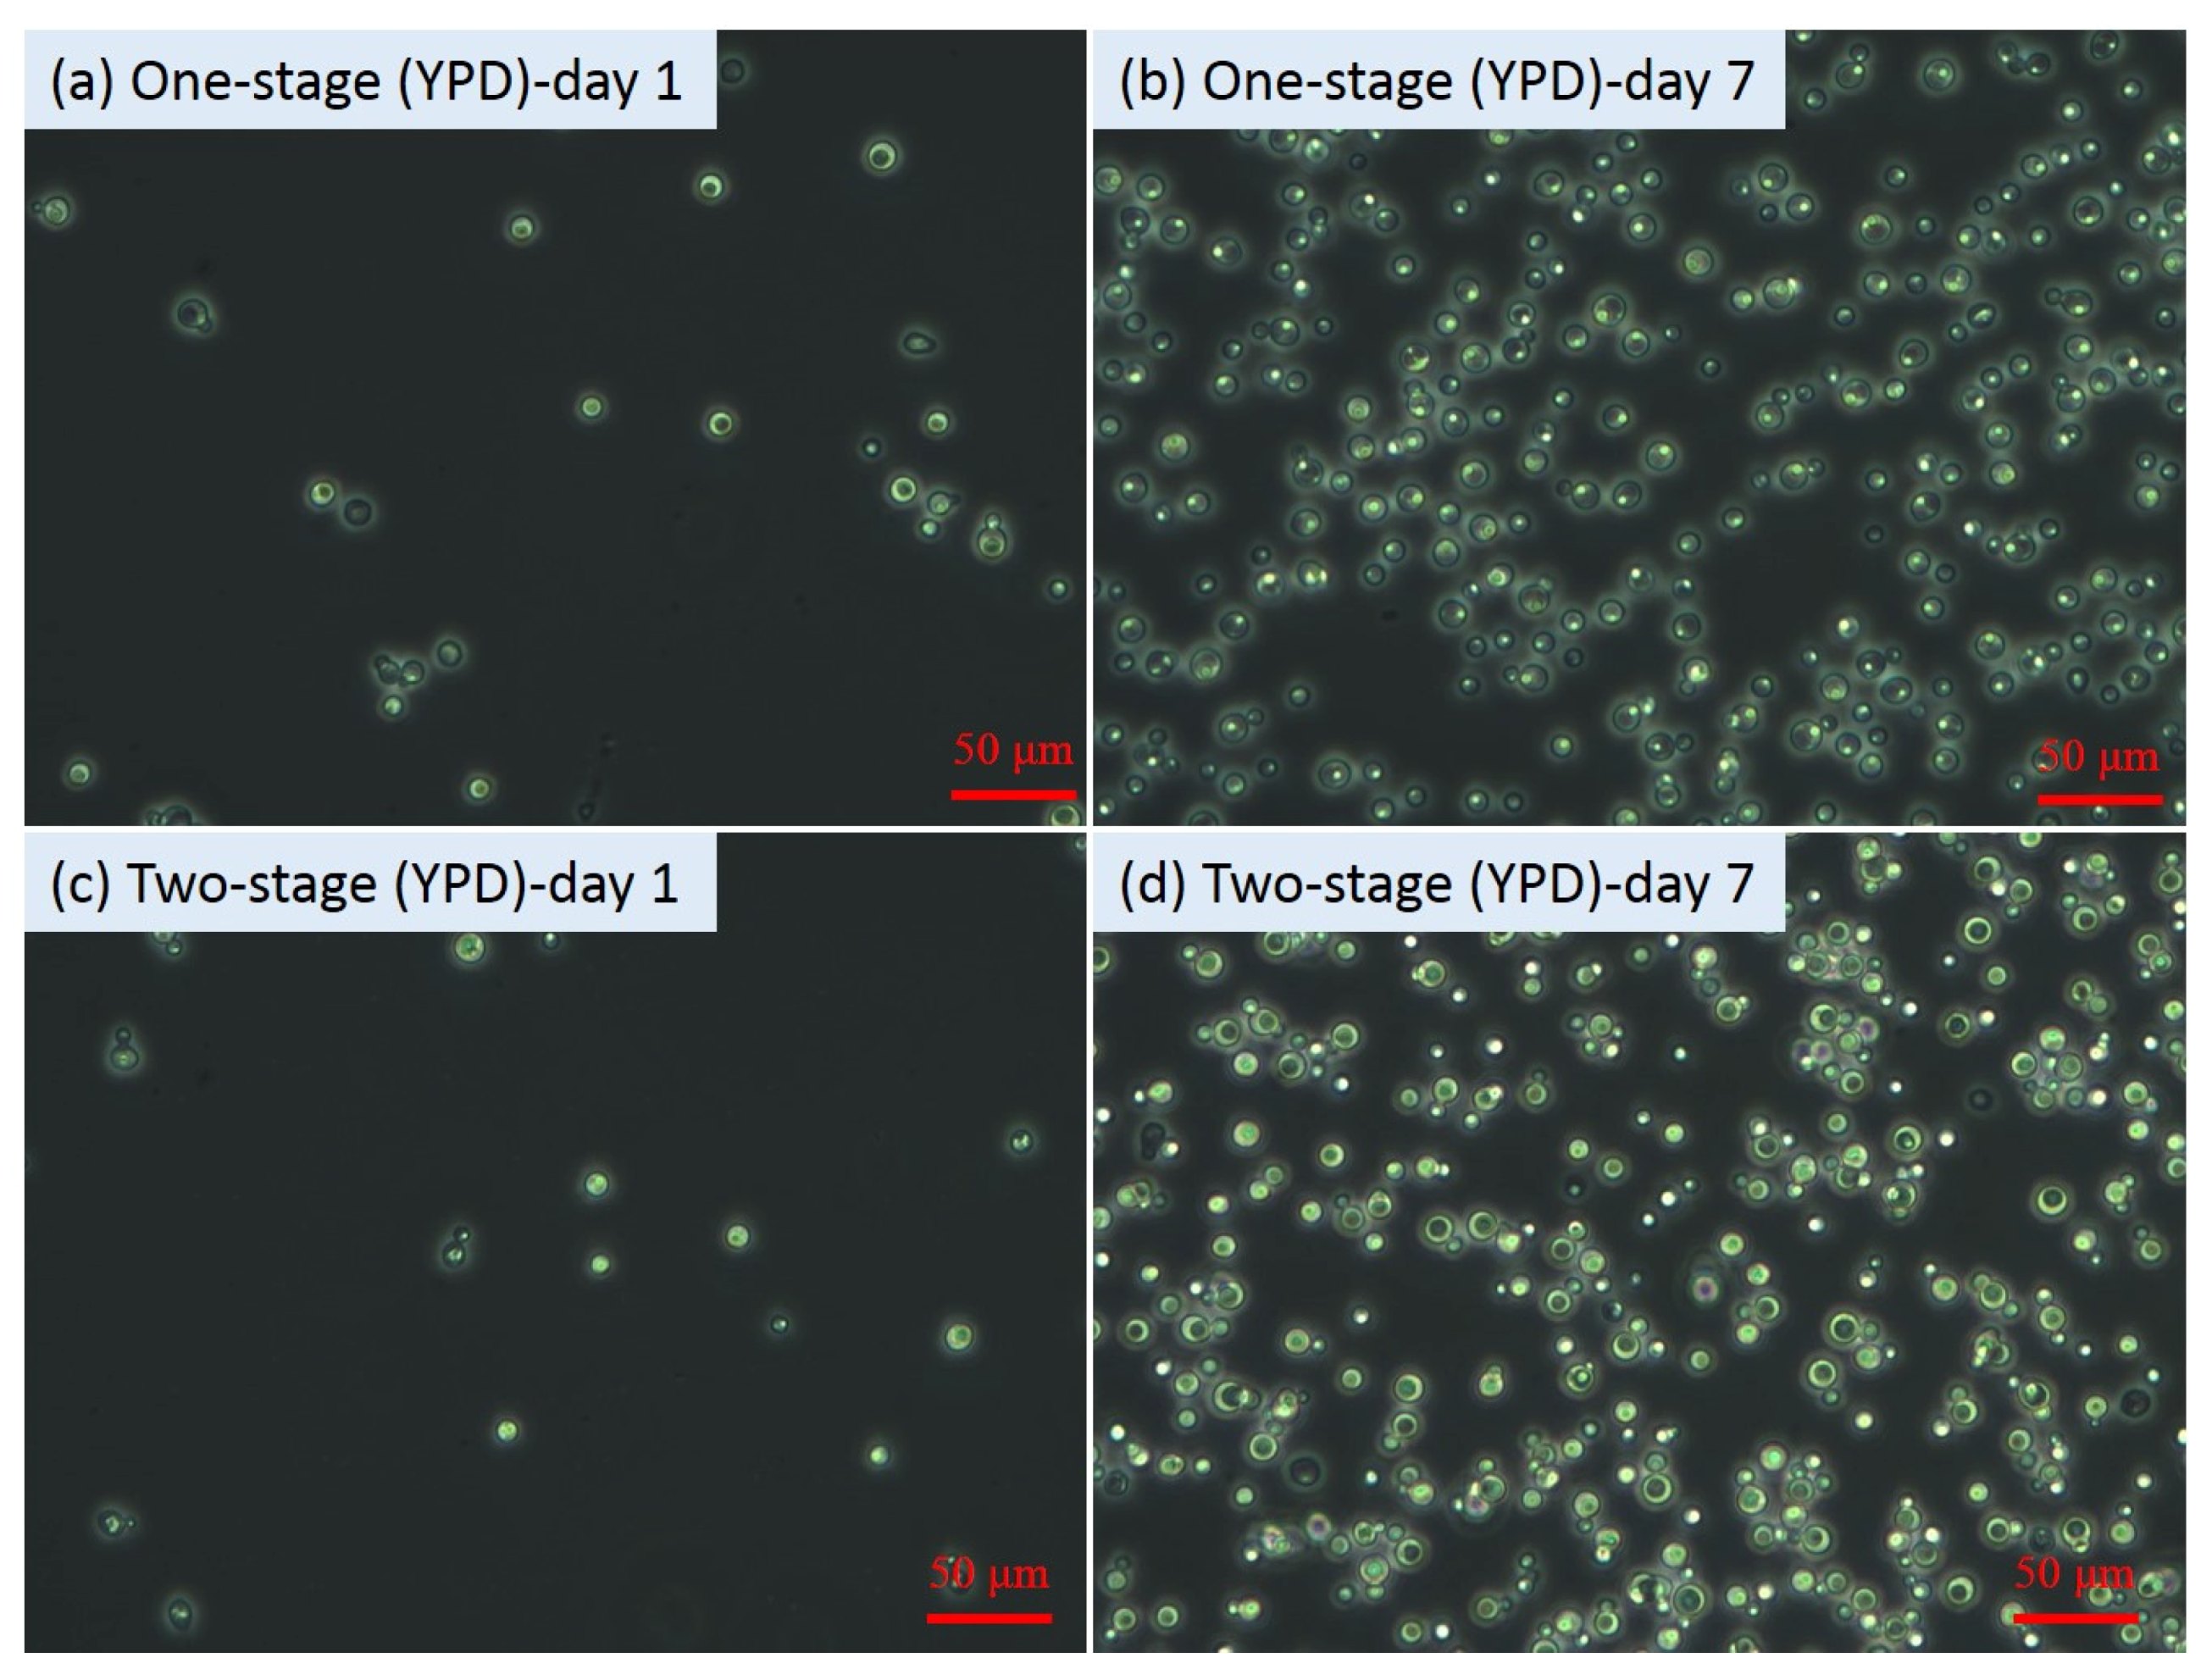
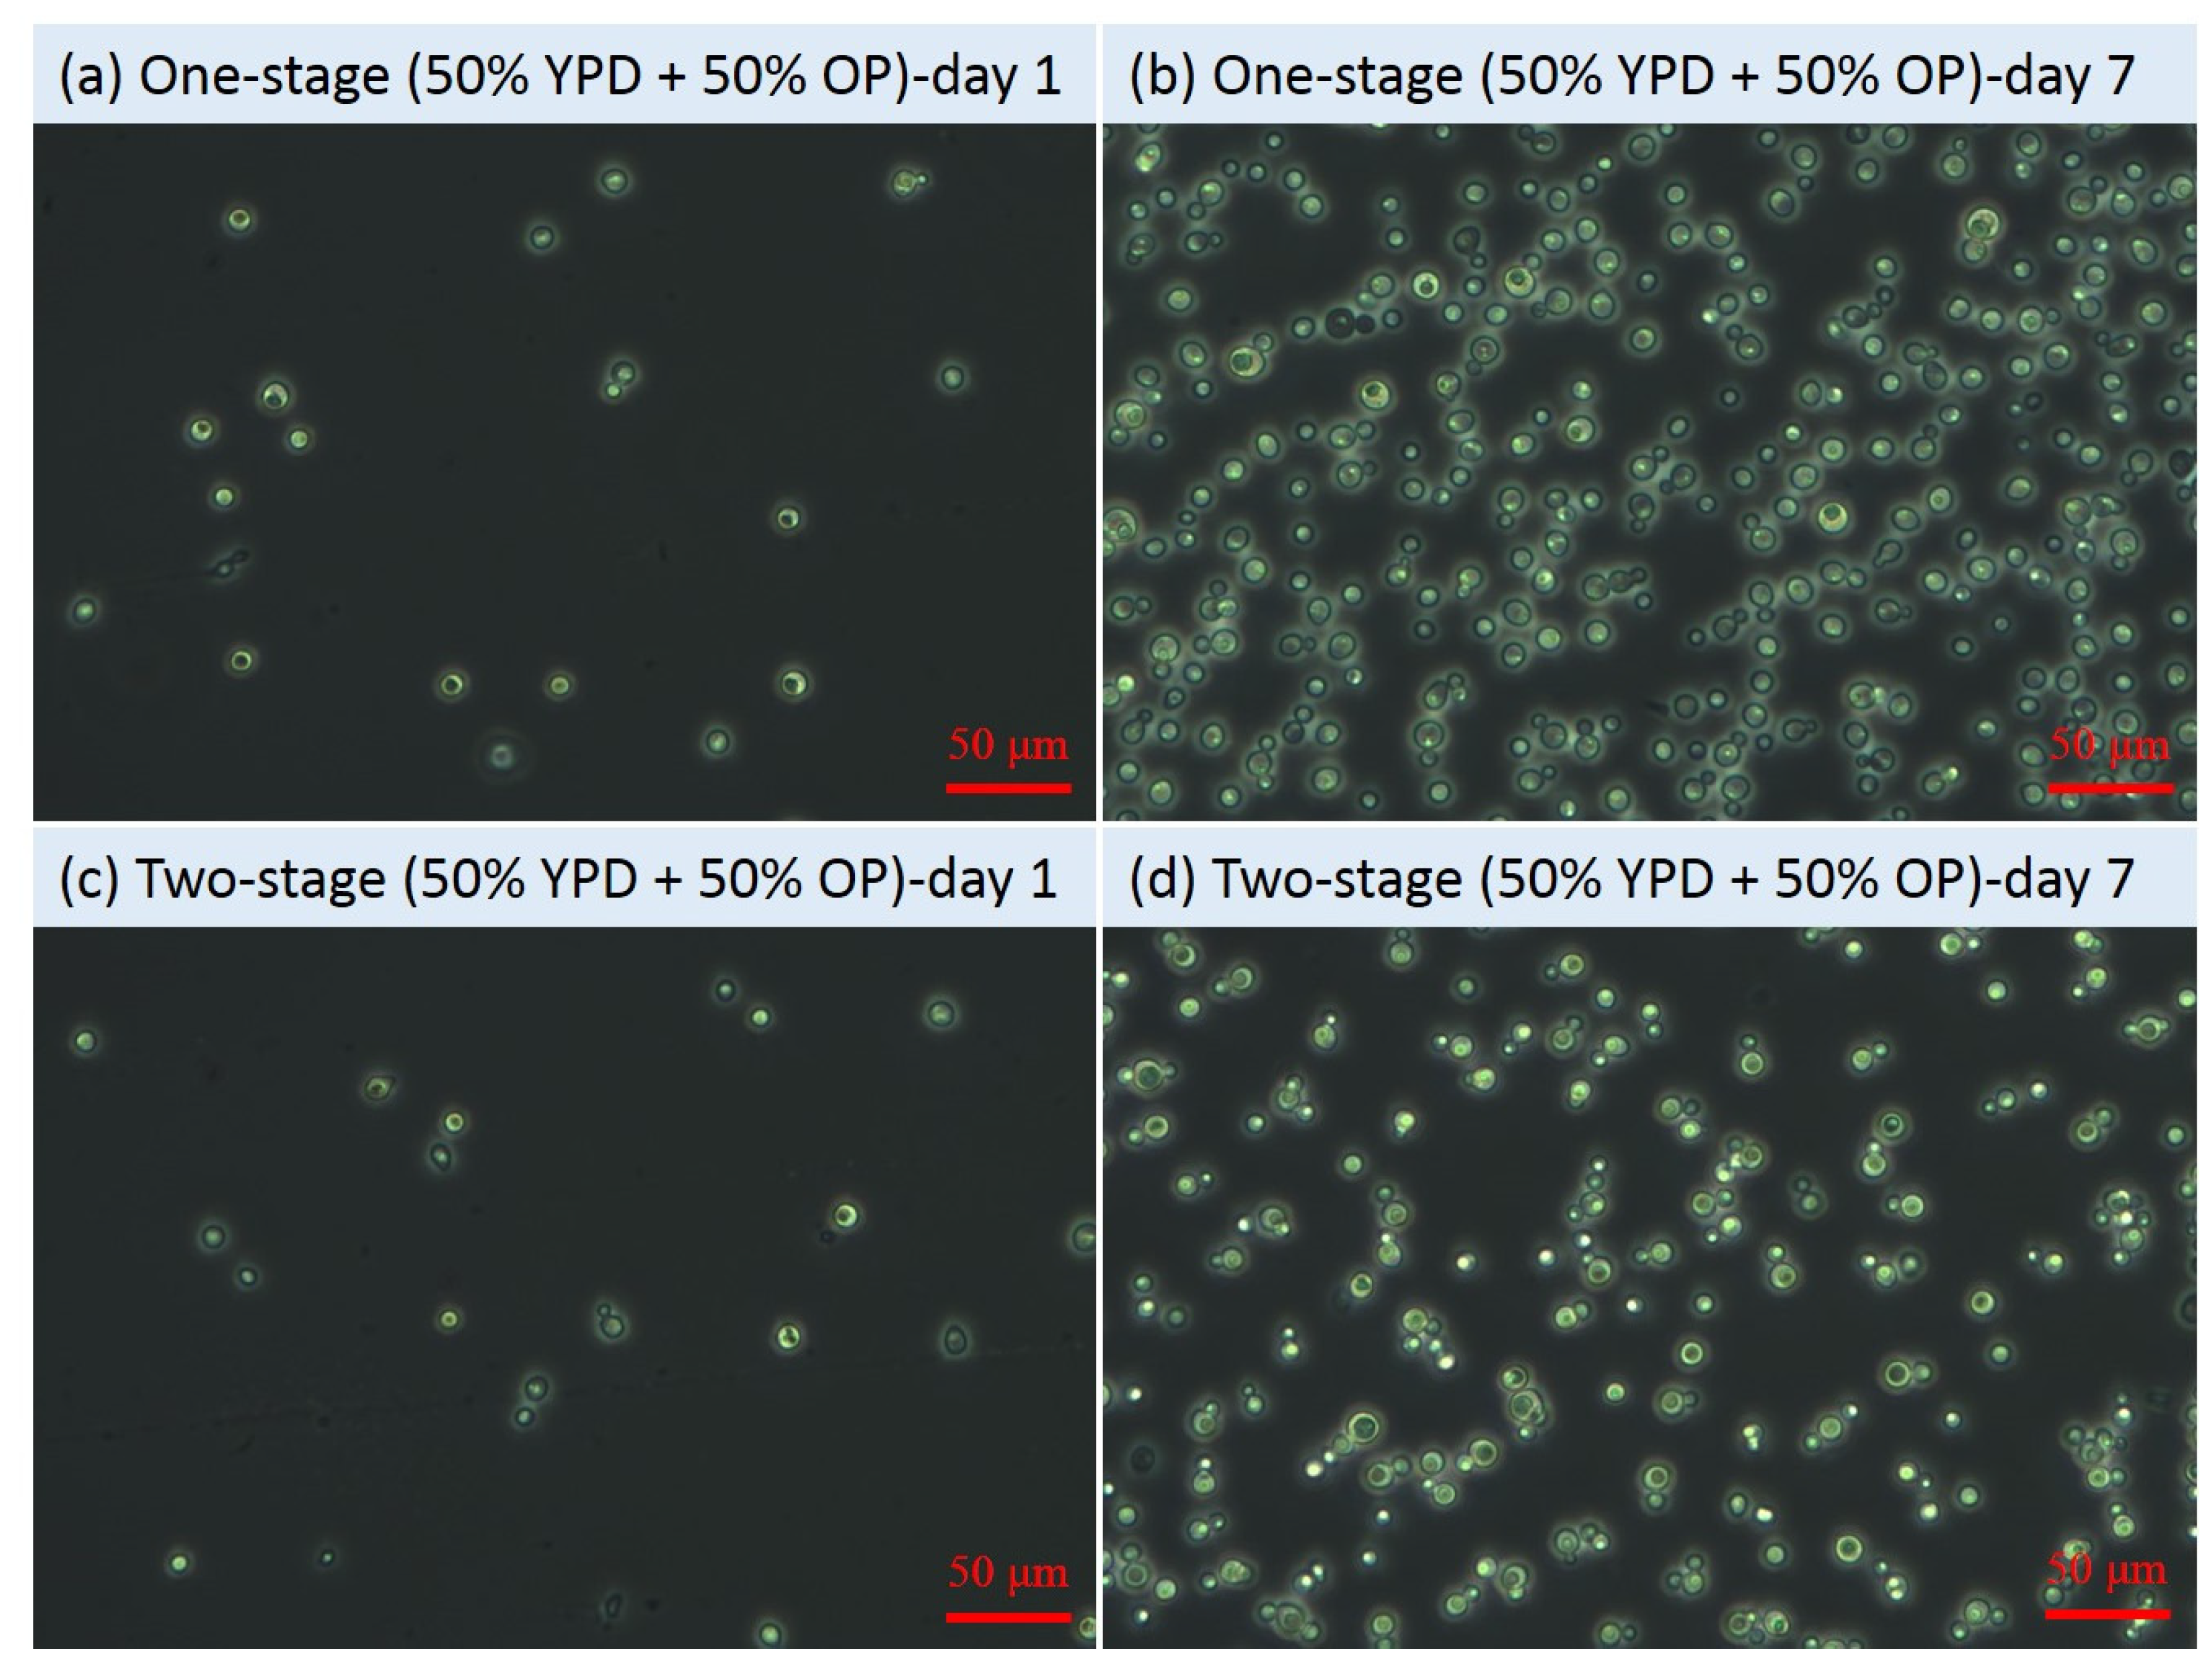

Two-Stage Fermentation of Lipomyces starkeyi for Production of Microbial Lipids and Biodiesel
Abstract
:1. Introduction
2. Materials and Methods
2.1. Feedstock
2.2. Pretreatment of OP for Recovery of Soluble Sugars
2.3. Yeast Strain and Medium
2.4. One-Stage and Two-Stage Fermentation of Yeast Using Commercial Sugars (YPD Medium) and OP Hydrolysate
2.5. Extraction of Microbial Lipids and Production of Biodiesel
2.6. Analytical Methods
2.7. Statistical Analysis
3. Results and Discussion
3.1. OD600, pH, and Microscopic Images of the Yeast Cells during Fermentation
3.2. C/N Ratio, TC Concentration, TN Concentration, Residual Sugar Concentration during Fermentation
3.3. Lipid Content and Lipid Titer during Fermentation
3.4. Fatty Acids Profile of the Lipid Samples of Lipomyces starkeyi after Fermentation
4. Conclusions
Author Contributions
Funding
Institutional Review Board Statement
Informed Consent Statement
Data Availability Statement
Acknowledgments
Conflicts of Interest
References
- Martani, F.; Maestroni, L.; Torchio, M.; Ami, D.; Natalello, A.; Lotti, M.; Porro, D.; Branduardi, P. Conversion of sugar beet residues into lipids by Lipomyces starkeyi for biodiesel production. Microb. Cell Factories 2020, 19, 1–13. [Google Scholar] [CrossRef] [PubMed]
- Tai, M.; Stephanopoulos, G. Engineering the push and pull of lipid biosynthesis in oleaginous yeast Yarrowia lipolytica for biofuel production. Metab. Eng. 2013, 15, 1–9. [Google Scholar] [CrossRef] [PubMed]
- Karmakar, B.; Halder, G. Progress and future of biodiesel synthesis: Advancements in oil extraction and conversion technologies. Energy Convers. Manag. 2019, 182, 307–339. [Google Scholar] [CrossRef]
- Ma, X.; Gao, Z.; Gao, M.; Wu, C.; Wang, Q. Microbial lipid production from food waste saccharified liquid under two-stage process. Bioresour. Technol. 2019, 289, 121626. [Google Scholar] [CrossRef]
- Patel, A.; Karageorgou, D.; Rova, E.; Katapodis, P.; Rova, U.; Christakopoulos, P.; Matsakas, L. An overview of potential oleaginous microorganisms and their role in biodiesel and omega-3 fatty acid-based industries. Microorganisms 2020, 8, 434. [Google Scholar] [CrossRef] [PubMed] [Green Version]
- Cho, H.U.; Park, J.M. Biodiesel production by various oleaginous microorganisms from organic wastes. Bioresour. Technol. 2018, 256, 502–508. [Google Scholar] [CrossRef] [PubMed]
- Xu, J.; Du, W.; Zhao, X.; Zhang, G.; Liu, D. Microbial oil production from various carbon sources and its use for biodiesel preparation. Biofuel. Bioprod. Biorefin. 2013, 7, 65–77. [Google Scholar] [CrossRef]
- Thanapimmetha, A.; Peawsuphon, N.; Chisti, Y.; Saisriyoot, M.; Srinophakun, P. Lipid production by the yeast Lipomyces starkeyi grown on sugars and oil palm empty fruit bunch hydrolysate. Biomass Convers. Biorefin. 2021, 11, 1197–1210. [Google Scholar] [CrossRef]
- Ma, X.; Gao, Z.; Gao, M.; Ma, Y.; Ma, H.; Zhang, M.; Liu, Y.; Wang, Q. Microbial lipid production from food waste saccharified liquid and the effects of compositions. Energy Convers. Manag. 2018, 172, 306–315. [Google Scholar] [CrossRef]
- Yousuf, A. Biodiesel from lignocellulosic biomass—Prospects and challenges. Waste Manage. 2012, 32, 2061–2067. [Google Scholar] [CrossRef]
- Ma, Y.; Liu, Y. Turning food waste to energy and resources towards a great environmental and economic sustainability: An innovative integrated biological approach. Biotechnol. Adv. 2019, 37, 107414. [Google Scholar] [CrossRef]
- Yang, X.; Jin, G.; Gong, Z.; Shen, H.; Song, Y.; Bai, F.; Zhao, Z.K. Simultaneous utilization of glucose and mannose from spent yeast cell mass for lipid production by Lipomyces starkeyi. Bioresour. Technol. 2014, 158, 383–387. [Google Scholar] [CrossRef]
- Sutanto, S.; Zullaikah, S.; Tran-Nguyen, P.L.; Ismadji, S.; Ju, Y.H. Lipomyces starkeyi: Its current status as a potential oil producer. Fuel Process. Technol. 2018, 177, 39–55. [Google Scholar] [CrossRef]
- Zhao, X.; Kong, X.; Hua, Y.; Feng, B.; Zhao, Z. Medium optimization for lipid production through co-fermentation of glucose and xylose by the oleaginous yeast Lipomyces starkeyi. Eur. J. Lipid Sci. Technol. 2008, 110, 405–412. [Google Scholar] [CrossRef]
- Takaku, H.; Matsuzawa, T.; Yaoi, K.; Yamazaki, H. Lipid metabolism of the oleaginous yeast Lipomyces starkeyi. Appl. Microbial Biotechnol. 2020, 104, 6141–6148. [Google Scholar] [CrossRef]
- McNeil, B.A.; Stuart, D.T. Lipomyces starkeyi: An emerging cell factory for production of lipids, oleochemicals and biotechnology applications. World J. Microbiol Biotechnol. 2018, 34, 1–10. [Google Scholar] [CrossRef] [PubMed]
- Calvey, C.H.; Su, Y.-K.; Willis, L.B.; McGee, M.; Jeffries, T.W. Nitrogen limitation, oxygen limitation, and lipid accumulation in Lipomyces starkeyi. Bioresour. Technol. 2016, 200, 780–788. [Google Scholar] [CrossRef] [PubMed] [Green Version]
- Angerbauer, C.; Siebenhofer, M.; Mittelbach, M.; Guebitz, G. Conversion of sewage sludge into lipids by Lipomyces starkeyi for biodiesel production. Bioresour. Technol. 2008, 99, 3051–3056. [Google Scholar] [CrossRef] [PubMed]
- Kumar, D.; Singh, B.; Korstad, J. Utilization of lignocellulosic biomass by oleaginous yeast and bacteria for production of biodiesel and renewable diesel. Renew. Sustain. Energy Rev. 2017, 73, 654–671. [Google Scholar] [CrossRef]
- Kamalini, A.; Muthusamy, S.; Ramapriya, R.; Muthusamy, B.; Pugazhendhi, A. Optimization of sugar recovery efficiency using microwave assisted alkaline pretreatment of cassava stem using response surface methodology and its structural characterization. J. Mol. Liq. 2018, 254, 55–63. [Google Scholar] [CrossRef]
- Yamazaki, H.; Kobayashi, S.; Ebina, S.; Abe, S.; Ara, S.; Shida, Y.; Ogasawara, W.; Yaoi, K.; Araki, H.; Takaku, H. Highly selective isolation and characterization of Lipomyces starkeyi mutants with increased production of triacylglycerol. Appl. Microbiol. Biotechnol. 2019, 103, 6297–6308. [Google Scholar] [CrossRef]
- Liu, W.; Mao, W.; Zhang, C.; Lu, X.; Xiao, X.; Zhao, Z.; Lin, J. Co-fermentation of a sugar mixture for microbial lipid production in a two-stage fermentation mode under non-sterile conditions. Sustain. Energ. Fuels 2020, 4, 2380–2385. [Google Scholar] [CrossRef]
- Bligh, E.G.; Dyer, W.J. A rapid method of total lipid extraction and purification. Can. J. Biochem. 1959, 37, 911–917. [Google Scholar] [PubMed] [Green Version]
- Chi, C.; Chang, H.-M.; Li, Z.; Jameel, H.; Zhang, Z. A method for rapid determination of sugars in lignocellulose prehydrolyzate. BioResources 2013, 8, 172–181. [Google Scholar] [CrossRef] [Green Version]
- Yook, S.D.; Kim, J.; Woo, H.M.; Um, Y.; Lee, S.-M. Efficient lipid extraction from the oleaginous yeast Yarrowia lipolytica using switchable solvents. Renew. Energy 2019, 132, 61–67. [Google Scholar] [CrossRef]
- Du, Y.; Cyprichová, V.; Hoppe, K.; Schuur, B.; Brilman, W. Process evaluation of swing strategies to recover N-ethylbutylamine after wet lipid extraction from microalgae. Sep. Purif. Technol. 2020, 233, 115819. [Google Scholar] [CrossRef]
- Selvakumar, P.; Sivashanmugam, P. Ultrasound assisted oleaginous yeast lipid extraction and garbage lipase catalyzed transesterification for enhanced biodiesel production. Energy Convers. Manag. 2019, 179, 141–151. [Google Scholar] [CrossRef]
- Zhang, L.; Loh, K.-C.; Sarvanantharajah, S.; Tong, Y.W.; Wang, C.-H.; Dai, Y. Mesophilic and thermophilic anaerobic digestion of soybean curd residue for methane production: Characterizing bacterial and methanogen communities and their correlations with organic loading rate and operating temperature. Bioresour. Technol. 2019, 288, 121597. [Google Scholar] [CrossRef]
- Lin, R.; Deng, C.; Ding, L.; Bose, A.; Murphy, J.D. Improving gaseous biofuel production from seaweed Saccharina latissima: The effect of hydrothermal pretreatment on energy efficiency. Energy Convers. Manag. 2019, 196, 1385–1394. [Google Scholar] [CrossRef]
- Van Soest, P.V.; Robertson, J.; Lewis, B. Methods for dietary fiber, neutral detergent fiber, and nonstarch polysaccharides in relation to animal nutrition. J. Dairy Sci. 1991, 74, 3583–3597. [Google Scholar] [CrossRef]
- Juanssilfero, A.B.; Kahar, P.; Amza, R.L.; Miyamoto, N.; Otsuka, H.; Matsumoto, H.; Kihira, C.; Thontowi, A.; Ogino, C.; Prasetya, B.; et al. Effect of inoculum size on single-cell oil production from glucose and xylose using oleaginous yeast Lipomyces starkeyi. J. Biosci. Bioeng. 2018, 125, 695–702. [Google Scholar] [CrossRef] [PubMed]
- Zhang, Z.; Li, Y.; Zhang, J.; Peng, N.; Liang, Y.; Zhao, S. High-titer lactic acid production by Pediococcus acidilactici PA204 from corn stover through fed-batch simultaneous saccharification and fermentation. Microorganisms 2020, 8, 1491. [Google Scholar] [CrossRef]
- Boviatsi, E.; Papadaki, A.; Efthymiou, M.N.; Nychas, G.J.E.; Papanikolaou, S.; da Silva, J.A.; Freire, D.M.G.; Koutinas, A. Valorisation of sugarcane molasses for the production of microbial lipids via fermentation of two Rhodosporidium strains for enzymatic synthesis of polyol esters. J. Chem. Technol. Biotechnol. 2020, 95, 402–407. [Google Scholar] [CrossRef]
- Pereira, A.M.; Pinna, C.; Biagi, G.; Stefanelli, C.; Maia, M.R.; Matos, E.; Segundo, M.A.; Fonseca, A.J.M.; Cabrita, A.R.J. Supplemental selenium source on gut health: Insights on fecal microbiome and fermentation products of growing puppies. FEMS Microbiol. Ecol. 2020, 96, fiaa212. [Google Scholar] [CrossRef]
- Li, P.; Xia, J.; Shan, Y.; Nie, Z.; Wang, F. Effects of surfactants and microwave-assisted pretreatment of orange peel on extracellular enzymes production by Aspergillus japonicus PJ01. Appl. Biochem. Biotechnol. 2015, 176, 758–771. [Google Scholar] [CrossRef] [PubMed]
- Lin, J.; Shen, H.; Tan, H.; Zhao, X.; Wu, S.; Hu, C.; Zhao, Z.K. Lipid production by Lipomyces starkeyi cells in glucose solution without auxiliary nutrients. J. Biotechnol. 2011, 152, 184–188. [Google Scholar] [CrossRef]
- Xavier, M.C.A.; Franco, T.T. Obtaining hemicellulosic hydrolysate from sugarcane bagasse for microbial oil production by Lipomyces starkeyi. Biotechnol. Lett. 2021, 43, 967–979. [Google Scholar] [CrossRef]
- Matsakas, L.; Sterioti, A.-A.; Rova, U.; Christakopoulos, P. Use of dried sweet sorghum for the efficient production of lipids by the yeast Lipomyces starkeyi CBS 1807. Ind. Crop. Prod. 2014, 62, 367–372. [Google Scholar] [CrossRef] [Green Version]
- Di Fidio, N.; Dragoni, F.; Antonetti, C.; De Bari, I.; Raspolli Galletti, A.M.; Ragaglini, G. From paper mill waste to single cell oil: Enzymatic hydrolysis to sugars and their fermentation into microbial oil by the yeast Lipomyces starkeyi. Bioresour. Technol. 2020, 315, 123790. [Google Scholar] [CrossRef]
- Islam, M.A.; Yousuf, A.; Karim, A.; Pirozzi, D.; Khan, M.R.; Wahid, Z.A. Bioremediation of palm oil mill effluent and lipid production by Lipomyces starkeyi: A combined approach. J. Clean. Prod. 2018, 172, 1779–1787. [Google Scholar] [CrossRef]
- Huang, C.; Chen, X.-F.; Yang, X.-Y.; Xiong, L.; Lin, X.-Q.; Yang, J.; Wang, B.; Chen, X.-D. Bioconversion of corncob acid hydrolysate into microbial oil by the oleaginous yeast Lipomyces starkeyi. Appl. Biochem. Biotechnol. 2014, 172, 2197–2204. [Google Scholar] [CrossRef]
- Amza, R.L.; Kahar, P.; Juanssilfero, A.B.; Miyamoto, N.; Otsuka, H.; Kihira, C.; Ogino, C.; Kondo, A. High cell density cultivation of Lipomyces starkeyi for achieving highly efficient lipid production from sugar under low C/N ratio. Biochem. Eng. J. 2019, 149, 107236. [Google Scholar] [CrossRef]
- Orsavova, J.; Misurcova, L.; Ambrozova, J.V.; Vicha, R.; Mlcek, J. Fatty acids composition of vegetable oils and its contribution to dietary energy intake and dependence of cardiovascular mortality on dietary intake of fatty acids. Int. J. Mol. Sci. 2015, 16, 12871–12890. [Google Scholar] [CrossRef] [PubMed]
- Di Fidio, N.; Ragaglini, G.; Dragoni, F.; Antonetti, C.; Raspolli Galletti, A.M. Integrated cascade biorefinery processes for the production of single cell oil by Lipomyces starkeyi from Arundo donax L. hydrolysates. Bioresour. Technol. 2021, 325, 124635. [Google Scholar] [CrossRef] [PubMed]

| Characteristics | Unit | Orange Peel |
|---|---|---|
| Extractives 1 | wt% 2 | 88.76 ± 4.76 |
| Cellulose | wt% 2 | 2.98 ± 0.68 |
| Hemicellulose | wt% 2 | 5.79 ± 1.11 |
| Lignin | wt% 2 | 0.47 ± 0.10 |
| Volatile solids (VS) | wt% 3 | 18.01 ± 0.37 |
| Total solids (TS) | wt% 3 | 23.96 ± 0.15 |
| VS/TS ratio | - | 0.752 |
| Carbon | wt% 2 | 41.14 ± 1.73 |
| Hydrogen | wt% 2 | 5.63 ± 0.19 |
| Nitrogen | wt% 2 | 1.00 ± 0.04 |
| C/N ratio | - | 41.14 |
| Flask Label | Fermentation Type | Fermentation Medium and Time | |
|---|---|---|---|
| First-Stage | Second-Stage | ||
| One-stage (YPD) | One-stage fermentation of commercial sugars | YPD medium; 7 d; Cell collection | Not applicable |
| Two-stage (YPD) | Two-stage fermentation of commercial sugars | YPD medium; 5 d; Cell collection; Transfer to the second stage | 60 g/L glucose; 1 d |
| One-stage (100% OP) | One-stage fermentation of bio-wastes-derived sugars | Modified bio-wastes-derived OP hydrolysate (with identical xylose and glucose concentration to YPD medium) 1; 7 d; Cell collection | Not applicable |
| Two-stage (100% OP) | Two-stage fermentation of bio-wastes-derived sugars | Modified bio-wastes-derived OP hydrolysate (with identical xylose and glucose concentration to YPD medium); 5 d; Cell collection; Transfer to the second stage | 60 g/L glucose; 1 d |
| One-stage (50% YPD + 50% OP) | One-stage fermentation of commercial sugars and bio-wastes-derived sugars | 50% YPD + 50% OP; 7 d; Cell collection | Not applicable |
| Two-stage (50% YPD + 50% OP) | Two-stage fermentation of commercial sugars and bio-wastes-derived sugars | 50% YPD + 50% OP; 5 d; Cell collection; Transfer to the second stage | 60 g/L glucose; 1 d |
Publisher’s Note: MDPI stays neutral with regard to jurisdictional claims in published maps and institutional affiliations. |
© 2021 by the authors. Licensee MDPI, Basel, Switzerland. This article is an open access article distributed under the terms and conditions of the Creative Commons Attribution (CC BY) license (https://creativecommons.org/licenses/by/4.0/).
Share and Cite
Zhang, L.; Lim, E.Y.; Loh, K.-C.; Dai, Y.; Tong, Y.W. Two-Stage Fermentation of Lipomyces starkeyi for Production of Microbial Lipids and Biodiesel. Microorganisms 2021, 9, 1724. https://doi.org/10.3390/microorganisms9081724
Zhang L, Lim EY, Loh K-C, Dai Y, Tong YW. Two-Stage Fermentation of Lipomyces starkeyi for Production of Microbial Lipids and Biodiesel. Microorganisms. 2021; 9(8):1724. https://doi.org/10.3390/microorganisms9081724
Chicago/Turabian StyleZhang, Le, Ee Yang Lim, Kai-Chee Loh, Yanjun Dai, and Yen Wah Tong. 2021. "Two-Stage Fermentation of Lipomyces starkeyi for Production of Microbial Lipids and Biodiesel" Microorganisms 9, no. 8: 1724. https://doi.org/10.3390/microorganisms9081724
APA StyleZhang, L., Lim, E. Y., Loh, K.-C., Dai, Y., & Tong, Y. W. (2021). Two-Stage Fermentation of Lipomyces starkeyi for Production of Microbial Lipids and Biodiesel. Microorganisms, 9(8), 1724. https://doi.org/10.3390/microorganisms9081724

